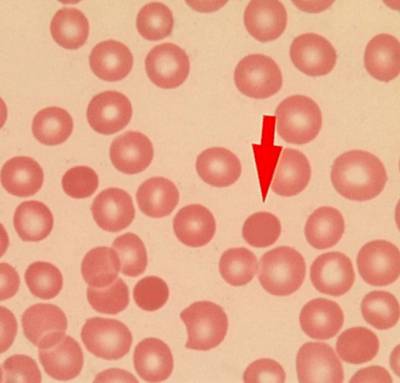

Содержание
- Информация о болезни
- Причины
- Признаки и симптомы
- Патолого-анатомическая картина
- Патогенез
- Как распознать наследственный сфероцитоз?
- Дифференциальный диагноз
- Лечение
- Распространённые лекарства
- Диета
- Профилактика
- Исход
- Осложнения и последствия
- Какой врач специализируется на данной болезни?
- Заключение
- Вопрос-ответ
- Советы
Эта болезнь относится к роду анемий и является наследственной патологией. Она имеет второе название – наследственный сфероцитоз. Первое описание её получено в XIX столетии физиологом Минковским и впоследствии дополнено Шоффаром. Патологии подвержены люди любого этнической группы и возраста. В группе риска находятся жители северной Европы.
Информация о болезни
У всех пациентов, у которых диагностирована патология, есть дефицит спектринов в мембране эритроцитов или нарушение их функционирования. Симптоматика и проявления патологии зависят от степени их дефицита.
Бывает, что у людей с дефицитом спектринов клинических проявлений болезни нет.
При этом заболевании эритроциты принимают форму сферы, превращаясь в сфероциты из-за аномалии белка мембраны клеток. Мембрана становится более проницаемой в неё попадает больше ионов натрия и лишняя вода.
Деформированные эритроциты в узких местах кровотока двигаются медленней, частично их поверхность расщепляется и они гибнут. Селезёнка производит их поглощение, её размеры из-за длительного поглощения разрушенных компонентов увеличиваются.
В организме увеличивается количество свободного билирубина, который выходит с каловыми массами. У пациентов его количество увеличивается до двадцати раз выше нормальных показателей.
Посмотрите видео на эту тему
https://youtube.com/watch?v=3jSknhVI3Ns
У больного начинают появляться камни в жёлчном пузыре и протоках.
Болезнь Минковского-Шоффара, редкое наследственное заболевание, вызывает интерес у врачей и исследователей. Это состояние связано с нарушением обмена веществ, в частности, с дефицитом фермента, отвечающего за расщепление определенных липидов. В результате этого накапливаются токсичные вещества, что приводит к повреждению клеток и тканей. Врачи подчеркивают, что симптомы могут варьироваться от легких до тяжелых, включая неврологические расстройства и проблемы с сердечно-сосудистой системой. Ранняя диагностика и комплексный подход к лечению имеют решающее значение для улучшения качества жизни пациентов. Специалисты рекомендуют генетическое консультирование для семей, в которых были случаи заболевания, чтобы повысить осведомленность и обеспечить своевременное вмешательство.

Причины
Природа патологии в основном носит наследственный характер. Зачастую один из родителей пациента имеет эту патологию.
Лишь в каждом четвёртом случае болезнь развивается вследствие новых мутаций в организме на протяжении жизни.
Признаки и симптомы
Клиническая картина может быть разнообразной и зависит от тяжести болезни, вида белка. Если в нём есть недостаточность а-цепи, то болезнь протекает легче. А вот поражение бета-цепи отличается тяжёлыми клиническими симптомами.
Наследственный сфероцитоз начинается уже после рождения ребёнка и по симптоматике похож на гемолитическую патологию или затянувшуюся гипербилирубинемию.
У пациента бледнеют кожные покровы, проявляет себя желтуха и спленоменалия.
Обычно заболевание протекает волнами. У пациента во время обострения инфекционных заболеваний развиваются кризы, но при этом они носить спонтанный характер. В период между кризами пациенты часто не жалуются на обострения болезни, но и в это время селезёнка остаётся увеличенной и легко прощупывается при пальпировании пальцами.
Между кризами у пациентов наблюдается симптоматика анемии. Человек ощущает постоянную слабость, у него бледнеет кожа и слизистые.
Кожа может приобретать жёлто-зелёный оттенок из-за увеличения распада эритроцитов. У пациента наблюдаются повышения температуры до 38 градусов, его мучают мигрени и ухудшается работоспособность.
В брюшной полости начинаются спастические болевые ощущения, увеличивается селезёнка.
Чем больше количество разрушенных эритроцитов, тем сильней симптомы патологии.
Болезнь Минковского-Шоффара — редкое генетическое заболевание, о котором в последнее время стало говорить больше благодаря усилиям врачей и пациентов. Люди, столкнувшиеся с этой болезнью, отмечают, что она проявляется в виде множественных нарушений, включая проблемы с кожей, суставами и внутренними органами. Многие пациенты делятся своими историями в социальных сетях, создавая сообщества поддержки, где обсуждают не только медицинские аспекты, но и эмоциональные переживания. Врачи подчеркивают важность ранней диагностики и индивидуального подхода к лечению, что может значительно улучшить качество жизни пациентов. Обсуждения на форумах показывают, что осведомленность о болезни растет, и это способствует поиску новых методов терапии и поддержки для тех, кто с ней сталкивается.

Особенности развития болезни у детей
Чем тяжелей течение патологии у пациента, тем сильней выражаются следующие признаки заболевания:
- Череп, принимающий форму башни.
- Готическое небо.
- Расширение переносицы.
- Увеличение расстояния между зубами.
Эти клинические проявления связаны с гиперплазией костного мозга и остеопорозом.
В некоторых случаях у человека проявляет себя только желтуха, а остальные симптомы просто не беспокоят. Иногда патология просто никак себя не проявляет, а выявляется после проведения соответствующих анализов.
Патолого-анатомическая картина
Костный мозг гиперплазируется в трубчатых и плоских костях и развивается эритрофагоцитоз.
У пациента в селезёнке уменьшается количество фолликулов и меняются их размеры, пульпа наполняется кровью.
В лимфе и печени врачи нередко диагностируют гемосидероз.
Патогенез
Дефективный белок, полученный человеком при рождении, вбирает в себя ионы натрия и воду. Форма эритроцитов становится сферической и разрушается при прохождении между узкими синусами селезёнки. Часть поверхности компонента крови отламывается и превращается в микросфероциты. Эти клетки быстро разрушаются и поглощаются селезёнкой. Этот процесс приводит к увеличению органа.
Кроме того, у пациента из-за увеличения уровня билирубина увеличивается вероятность появления камней в жёлчных протоках и пузыре.
Как распознать наследственный сфероцитоз?
Алгоритм диагностирования заболевания
- Сбор информации со слов пациента о его наследственности
- Анализ крови
- Исследование и определение среднего диаметра эритроцитов
- Кривая Прайс-Джонса
- Исследование эритроцитов на стойкость
- Анализ свободного и связанного билирубина
- Пункция костного мозга
- Анализ сыворотки крови на наличие железа
- Исследование мочи на наличие жёлчного пигмента
Что нужно обследовать?
Для выявления заболевания пациенту следует взять кровь на анализ, а также обследовать селезёнку.
Как нужно проводить анализы?
В качестве профилактики необходимо проводить общий анализ крови с тестом на болезнь Минковского-Шоффара хотя бы раз в 12 месяцев.
Какие необходимы анализы
Анализ крови
Для выявления заболевания достаточно провести анализ крови. При микроскопии мазка, окрашенного по Романовскому-Гимзе видны эритроциты, которые изменили свою форму. Лаборант проводит анализ и подсчёт поражённых компонентов крови и на основании этого определяет тяжесть патологии. Значительным считается отклонение в 10–20% от всего количества эритроцитов.
Анализ крови помогает выявлять разные формы анемии, лейкоцитоз и увеличение уровня СОЭ.
Также врачи рекомендуют человеку пройти биохимию. В таком анализе можно выявить увеличение количества железа в сыворотке крови или непрямого билирубина.
Иногда проводится проба Кумбса.
А также рекомендуется пройти УЗИ селезёнки.

Клинические признаки болезни в большинстве случаев можно увидеть невооружённым глазом. Это деформированные кости черепа, желтушность кожных покровов, увеличенные размеры селезёнки, нарушение анатомической формы эритроцитов.
Важна и беседа с самим пациентом, который поможет опровергнуть или подтвердить наследственную версию патологии крови.
Затрудняет диагностирование желчнокаменная болезнь, если она присутствует у человека.
Дифференциальный диагноз
Похожие симптомы могут встречаться и у других пациентов, которым диагностированы иммунные гемолитические анемии.
Но при этой болезни не встречается деформированных костей черепа и не проявляются наследственные признаки болезни. При гемолизе нет увеличения селезёнки, не болит жёлчный пузырь.
Если врач сомневается, то верное решение поможет найти проба Кумбса.
В основном этот анализ бывает положительным только при гемолитической анемии, а при микросфероцитозе проба отрицательная.
Лечение
Современные методики
Терапия, которая назначается при этом заболевании зависит от того насколько часто у пациента начинается криз, от течения патологии и возраста самого пациента.
Во время криза рекомендуется срочная госпитализация человека и лечение болезни с целью предотвращения отёка головного мозга, гипербилирубинии и т. д.
При тяжёлых формах болезни врачи рекомендуют переливать эритроциты, а после того как человек выйдет из криза ему назначается специальная диета и режим дня.
Консервативные методики
Во время спокойного течения патологии без кризов вмешательство врачей не требуется. Если у пациента начинается приступ, то его в экстренном порядке госпитализируют и проводятся следующие меры воздействия:
- Замещение эротиритарной массы при падении гемоглобина до критических показателей.
- Если билирубин высокий, то пациенту проводят терапию альбуминами.
- Для того, чтобы организм не отравлялся токсинами, пациенту проводят инфузионную терапию.
- Когда наступает период без ярко выраженных кризов человеку назначается приём желчегонных медикаментов. Дозировки и сами препараты назначаются врачом с учётом индивидуальных особенностей организма пациента.
Оперативное вмешательство
Если болезнь протекает тяжело и невозможно справиться вышеуказанными способами, то пациенту рекомендуют удаление селезенки. Это не помогает полностью справиться с патологией, но в организме уменьшается количество деформированных эритроцитов. Жизненный цикл эритроцитов в организме увеличивается.
Как правило, после хирургического вмешательства кризы не повторяются. Но этот метод рекомендован далеко не всем. Например, не делают операции по удалению этого органа детям возрастом до 5 лет, в связи с высокой смертностью.
После такой операции организм хуже сопротивляется грибковым инфекциям и вирусам.
Альтернативой может стать эндоваскулярная окклюзия. Врач вводит в селезенку лекарственное средство, которое вызывает её инфаркт.
Но некоторая часть органа полноценно снабжается кровью и может справляться с инфекциями.
Распространённые лекарства




Диета
Основа питания при этой болезни: увеличение количества фолиевой кислоты в рационе пациента до 200 мкг в сутки.
Разрешённые продукты
- хлеб и выпечка из муки грубого помола
- пюрезированные сырые овощи, например, морковь, цветная капуста
- грибы разных видов
- гречка, пшёнка, фасоль
- овсяная крупа
- говяжья печень
- творог высокой жирности
- любые виды сыра
Запрещённые продукты
Врачи не выделяют особых групп запрещённых продуктов при этой болезни, но отмечают, что во время криза рекомендуется есть именно продукты с повышенным содержанием фолиевой кислоты.
Пример меню на день
День первый
- Чай с тостом из муки грубого полома и кусочком сыра.
- Тушёная говяжья печень со сметаной. Пюре из цветной капусты.
- Творог с добавлением ягод.
- Кисель из овсяных хлопьев.
День второй
- Компот из сухофруктов с галетами.
- Гречневая каша с кусочком телятины и салат из овощей.
- Булочка с кусочком сыра.
- Гарнир из пшённой каши с овощами.
- Чай с печёным яблоком.
День третий
- Кефир малой жирности с галетами.
- Овощное рагу с грибами.
- Кисель из ягод и печенье.
- Отварная фасоль с говяжьей печенью.
Профилактика
Профилактические меры по предупреждению болезни Минковского-Шоффара заключаются только в консультации с генетиком перед зачатием ребёнка. Остальные методы неэффективны.
Врач сможет оценить вероятность появления у малыша этого заболевания и выявит есть ли дефектный ген в его организме у родившегося ребёнка.
Остальные профилактические меры просто сводятся к лечению во время обострений патологии (кризов).
Исход
При лёгких степенях патологии и своевременно проведённой терапии безусловно прогноз будет благоприятным. Болезнь проявляет себя волнообразно, сменяясь то спокойным течением, то кризами с ухудшением состояния больного. Ремиссия после криза может быть от нескольких недель или месяцев до нескольких лет.
В это время состояние пациента не ухудшается.
Осложнения и последствия
Чем грозит это заболевание пациенту? Чаще всего это развитие желчнокаменной болезни из-за нарушения билирубинового обмена. В этом случае врачи рекомендуют проводить холецистэктомию. Если её не сделать, то в жёлчных протоках со временем образуются камни.
Ещё одно осложнение болезни — это появление трофических язв с последующим тромбированием сосудов и ишемией.
Реже развиваются арегенераторные кризы, из-за которых количество билирубина падает, а анемия усиливается.
Врачи считают, что этому явлению способствует развивающийся в организме человека парвовирус.
Какой врач специализируется на данной болезни?
Для диагностирования и лечения патологии необходимо пройти консультацию врача-гематолога.
Заключение
Болезнь Минковского-Шоффара является, в основном, наследственным заболеванием, которое оказывает негативное воздействие на весь организм и способствует деформированию костей. Болезнь развивается волнообразно, чередуя периоды кризов и ремиссий. Для ее лечения врачи рекомендуют консервативное лечение с помощью медикаментов и специальной диеты.
В тяжелых случаях пациентам предлагают хирургическое вмешательство в виде удаления печени или желчного пузыря.
К сожалению, даже такие радикальные меры не способны вылечить болезнь полностью. Профилактических мер по предупреждению заболевания тоже практически не существует.
Вопрос-ответ
Что такое болезнь Минковского-Шоффара?
Наследственный микросфероцитоз или болезнь Минковского-Шоффара — генетическое заболевание с аутосомно-доминантным типом наследования. Заболевание характеризуется нарушением структуры мембраны эритроцитов, в результате чего происходит изменение формы эритроцитов и их гемолиз в селезёнке.
Что такое сфероцитоз Минковского-Шоффара?
Наследственный сфероцитоз (анемия Минковского-Шоффара) является наиболее распространенной причиной гемолитической анемии из-за аномальной мембраны эритроцитов и классифицируется как тип врожденной гемолитической анемии. Эритроциты содержат гемоглобин, который переносит кислород по всему телу.
Каковы симптомы болезни Минковского-Шоффара?
Ранние симптомы включают анемию, желтуху, спленомегалию и утомляемость. Острые случаи могут привести к гипоксии, вызванной анемией, и острой ядерной желтухе из-за высокого уровня билирубина в крови, особенно у новорожденных. Большинство случаев можно обнаружить вскоре после рождения.
Советы
СОВЕТ №1
Изучите основные симптомы болезни Минковского-Шоффара, такие как отеки, боли в суставах и кожные высыпания. Это поможет вам своевременно распознать заболевание и обратиться к врачу для диагностики.
СОВЕТ №2
Обратите внимание на генетическую предрасположенность в вашей семье. Если у вас есть родственники с этой болезнью, обсудите с врачом возможность проведения генетического тестирования для оценки риска.
СОВЕТ №3
Следите за своим образом жизни: сбалансированное питание, регулярные физические нагрузки и отказ от вредных привычек могут помочь снизить риск обострений и улучшить общее состояние здоровья.
СОВЕТ №4
Не забывайте о важности регулярных медицинских осмотров. Консультации с врачом помогут вам контролировать состояние и получать актуальную информацию о новых методах лечения и управления заболеванием.

